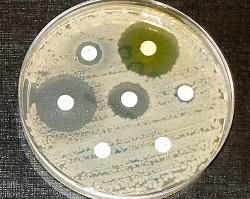

De gebruiken van Buah Merah

Buah Merah, ook bekend als rood fruit is een prachtige plant dat groeit in Papua Nieuw Guinea. De plant is daar ontdekt en gebruikt door de bewoners van de Timika en Wamena, twee steden in centraal Papoea.
De helende eigenschappen van de plant werden begin deze eeuw door dr. Budi ontdekt, na een reis door Papoea. Hij zag de inheemse medicijnmannen grote dosissen van de plant innemen en toedienen om ziektes te bestrijden.

Door het verassende gebruik van een opvallende rode maiskolf, besloot dr. Budi onderzoek te doen. Uit zijn onderzoek bleek dat Buah Merah enorm rijk is aan antioxidanten. In een vergelijkende studie werd gezien dat Buah Merah een 36 keer sterker oxidatie tegen gaat dan vitamine C! (1) Antioxidanten zijn niet alleen nodig voor een gezond lichaam, maar worden ook veel gebruikt in de huidverzorging (Bekijk onze vorige blog om meer info te krijgen over Buah Merah en huidverzorging!)
Het onderzoek van Dr. Budi toont aan dat de plant rijk is aan antioxidanten, wat het natuurlijke immuunsysteem versterkt. Wanneer het lichaam veel werkt, is er meer oxidatie in het lichaam en dit veroorzaakt schade. Te veel schade in een keer kan zorgen voor ziekte. Geen wonder dat de medicijnmannen uit Papoea deze plant gebruikt tegen ziekte.
Antibacteriële werking van Buah Merah
Er is een andere reden dat Buah Merah wordt gebruikt tegen ziekte. Uit hetzelfde onderzoek blijkt dat Buah Merah bacteriegroei kan remmen. Er zijn zes stammen van bacteriën bekeken, waaronder S. Aureus en E. Coli. Deze bacteriën zitten op je huid en in de ontlasting. Wanneer Buah Merah toegediend werd, zagen de onderzoekers een ring van 18 cm waar geen bacteriën groeiden. Dit betekent een sterke antibacteriële werking! (2)
Petrischaal met kleine schijven antibiotica. Des te groter de leegte, des te beter het antibioticum werkt.
Wil je ook de voordelen van Buah Merah ervaren? Kijk dan in de shop voor de mogelijkheden. Voor beginners wordt de olie aangeraden, zo kun je elke ochtend twee tot drie druppels innemen tijdens het ontbijt voor de antioxidanten. Maak je je meer druk om een infectie? Dan is het handig om wat meer in te nemen. Tegen rimpels? Smeer de olie dan op de huid.
Er zijn vele gebruiken voor deze olie en vrucht. Houdt de blog in de gaten om meer te weten over Buah Merah!

Bronnen
- Kim M-Z, Kim K-H, Jang H, Yook H-S. Evaluation of Antioxidant and Antimicrobial Activity of Buah Merah (<i>Pandenus conoideus</i>) by Solvent Fractionation. Journal of the Korean Society of Food Science and Nutrition. 2021;50(8):792-8.
- Indrawati I, editor Sensitivity of pathogenic bacteria to buah merah (Pandanus conoideus Lam.)2016: Author(s).





